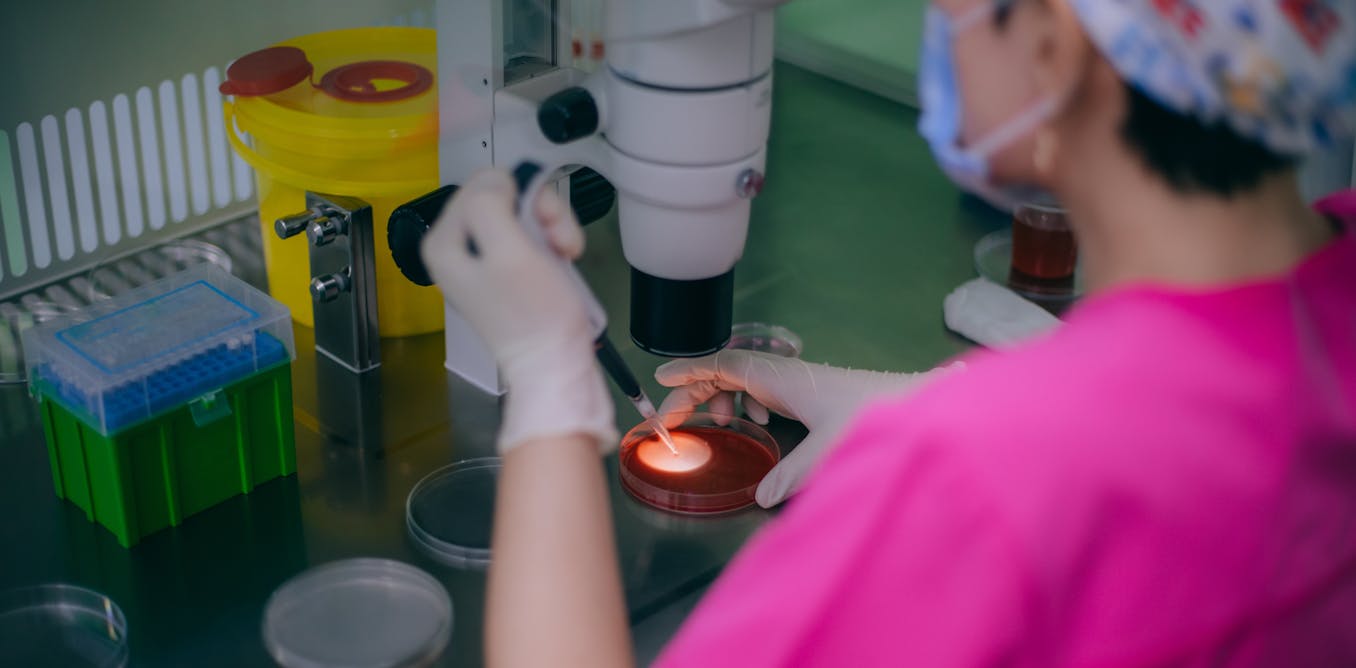
Pruebas genéticas en reproducción asistida: entre las promesas de salud y el ‘marketing’ dudoso

Pruebas genéticas en reproducción asistida: entre las promesas de salud y el ‘marketing’ dudoso
Existen miles de enfermedades genéticas y a muchas parejas les preocupa transmitirlas. La tecnología de reproducción asistida ofrece una solución con la prueba genética preimplantacional o PGT, que analiza los embriones antes de implantarlos para descartar los no saludables. Su uso ha aumentado drásticamente en España.
El PGT incluye tres variantes. Mientras que dos son para prevenir enfermedades hereditarias específicas, la tercera, el PGT-A, se ofrece a cualquier persona en fecundación in vitro, aunque su eficacia es muy debatida y algunos estudios indican que podría reducir las tasas de éxito al descartar embriones viables. En España, al ser un sector muy comercial y privatizado, el PGT-A es común y se vende como un complemento extra.
Estudios revelan que las clínicas comunican esta tecnología con un discurso a medio camino entre la divulgación y la publicidad, sin aclarar las diferencias entre las variantes ni las incertidumbres del PGT-A. La comercialización se dirige directamente a las mujeres, usando eslóganes que refuerzan estereotipos maternales. Se insiste en la edad materna y el "reloj biológico", presentando el test como un seguro racional contra el tiempo y un acto de amor para prevenir el sufrimiento. Esto sitúa a las mujeres como principales responsables del bienestar del embrión, entrelazando lógicas biomédicas, económicas y afectivas.
La proliferación de estas innovaciones en un ámbito tan comercial ofrece oportunidades, pero estas tecnologías no son neutrales. La forma en que se presentan influye en cómo entendemos la maternidad y la responsabilidad genética. Por eso, es fundamental una comunicación clara y honesta que priorice el bienestar de las personas por encima de los intereses del mercado.
Contenido original en http://dbbeebom
Si cree que algún contenido infringe derechos de autor o propiedad intelectual, contacte en bitelchux@yahoo.es.
Copyright notice
If you believe any content infringes copyright or intellectual property rights, please contact bitelchux@yahoo.es.